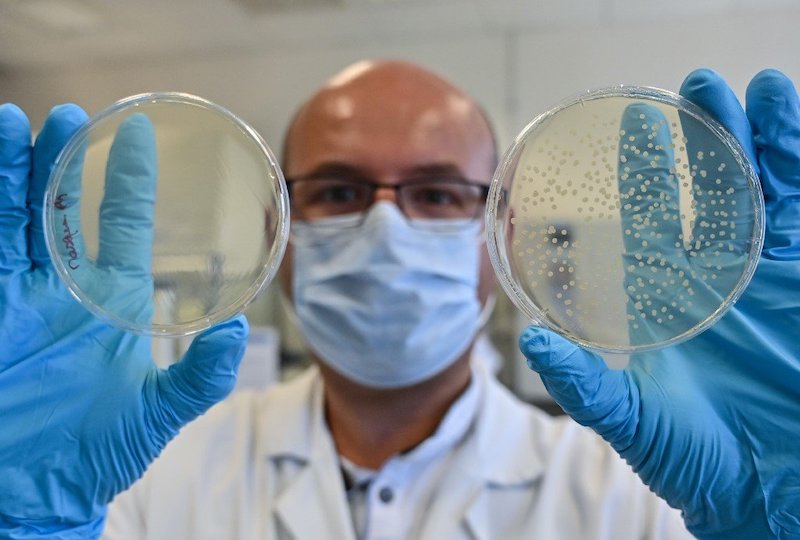

-
 Las muestras en Quito se podrán tomar desde los autos. Foto: Archivo.
Las muestras en Quito se podrán tomar desde los autos. Foto: Archivo.
El Ministerio de Salud autorizó dicha medida a partir del cambio del color.
El Ministerio de Salud autorizó que las muestras para pruebas de COVID-19 se tomen en el interior de los vehículos de los pacientes en la ciudad de Quito, a partir del cambio del color de semáforo.
Con el servicio al auto, el objetivo es reducir los contagios ya que en la capital se reporta un incremento de la demanda en los laboratorios particulares por este examen.
Jéssica Argotti, gerente de un centro médico indicó que el paciente puede agendar una cita vía telefónica previamente y acude a tomarse la muestra en su vehículo, en el estacionamiento.
En dicho lugar, el paciente es atendido por un equipo de especialistas que toman los signos vitales y que vigilan todos los detalles de bioseguridad.
La iniciativa llama la atención de los clientes que en 20 minutos obtienen sus resultados de la pruebas rápidas y las de PCR en 48 horas que les llegan a su correo electrónico y tOdo sin bajarse del auto.
Recomendadas